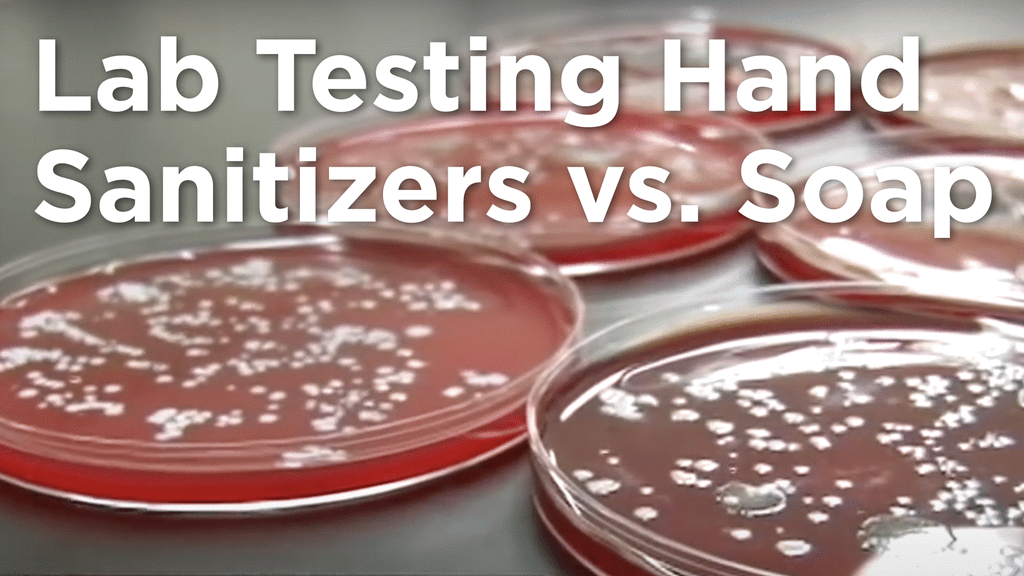
Lab Testing Hand Sanitizers Vs Soap The Healing Tree Lab Testing Hand Sanitizers Vs Soap The Healing Tree

29+ Abc news on hand sanitizer vs soap and water ideas
Home » Wallpapers » 29+ Abc news on hand sanitizer vs soap and water ideasYour Abc news on hand sanitizer vs soap and water images are available in this site. Abc news on hand sanitizer vs soap and water are a topic that is being searched for and liked by netizens today. You can Download the Abc news on hand sanitizer vs soap and water files here. Find and Download all royalty-free photos.
If you’re searching for abc news on hand sanitizer vs soap and water pictures information related to the abc news on hand sanitizer vs soap and water keyword, you have pay a visit to the right blog. Our website always gives you suggestions for seeking the maximum quality video and picture content, please kindly hunt and find more informative video articles and images that match your interests.
Abc News On Hand Sanitizer Vs Soap And Water. Hand sanitizers work in very much the same way as water and soap. For this reason the CDC recommends soap and water as the primary most effective germ-buster. What if you have coronavirus but dont know you have it. Youve seen them everywhere.
 The 9 Best Hand Soaps To Fight Germs 2021 This Old House From thisoldhouse.com
The 9 Best Hand Soaps To Fight Germs 2021 This Old House From thisoldhouse.com
Hand sanitizer is more portable. Should you use soap and water or hand sanitiser. Should you wear a mask. ABC News reported that during the pandemics first months eBay banned the sale of hand sanitizer disinfectant wipes and surgical masks by US. Keeping their hands clean is a big. Kids who cleaned their hands using hand sanitizer instead of soap and water missed less school according to a new study.
ABC News reported that during the pandemics first months eBay banned the sale of hand sanitizer disinfectant wipes and surgical masks by US.
Kids who cleaned their hands using hand sanitizer instead of soap and water missed less school according to a new study. CINCINNATI WKRC - Whats better at fighting germs and keeping you from getting sick– hand washing or hand sanitizers. Soap and water are more effective than hand sanitizers at removing certain kinds of germs like Cryptosporidium norovirus and Clostridium difficile 1-5. Kids who cleaned their hands using hand sanitizer instead of soap and water missed less school according to a new study. An ABC News report tested alcohol-based hand sanitizers antibacterial soap and regular soap and found that alcohol-based hand sanitizers were able to. Hand sanitizers work in very much the same way as water and soap.
 Source: youtube.com
Source: youtube.com
Soap and water is more. Hand Sanitizer in Daycare Centers. Keeping their hands clean is a big. Now a study out of Spain reveals that children under 3 years old who attend daycare centers a population vulnerable to the. Soap and water are also part of a hand-cleansing routine thats.
 Source: abcnews.go.com
Source: abcnews.go.com
What if you have coronavirus but dont know you have it. However without the use of water hand sanitizer uses the active ingredient of alcohol to. Youve seen them everywhere. ABC News reported that during the pandemics first months eBay banned the sale of hand sanitizer disinfectant wipes and surgical masks by US. Hand sanitizer vs.
 Source: thestreet.com
Source: thestreet.com
Thats because soap and water are simply more thorough. What if you have coronavirus but dont know you have it. CINCINNATI WKRC - Whats better at fighting germs and keeping you from getting sick– hand washing or hand sanitizers. Interestingly enough the Food and Drug Administration in regards to regulations concerning proper procedures for food. However without the use of water hand sanitizer uses the active ingredient of alcohol to.
 Source: komonews.com
Source: komonews.com
Hand Sanitizer in Daycare Centers. CINCINNATI WKRC - Whats better at fighting germs and keeping you from getting sick– hand washing or hand sanitizers. Youve seen them everywhere. Hand sanitizer may kill viruses and certain bacteria but it does not clean your hands like soap and. What if you have coronavirus but dont know you have it.
 Source: shethepeople.tv
Source: shethepeople.tv
Should you wear a mask. Which one should you use. Soap and water is more. Hand Sanitizer in Daycare Centers. Hand Sanitizers vs.
 Source: npr.org
Source: npr.org
For this reason the CDC recommends soap and water as the primary most effective germ-buster. March 4 2020. Hand sanitizer vs. Keeping their hands clean is a big. Handwashing also removes debris.
 Source: youtube.com
Source: youtube.com
Hand Sanitizers vs. While I am an advocate for hand hygiene I am not an advocate in the community for the overuse of alcohol-based hand rubs or medicated soaps Old-fashioned soap. Hand sanitizers work in very much the same way as water and soap. And yet the hand sanitizer wasnt even as effective as washing with water alone which inactivated the virus within 30 seconds. Thats because soap and water are simply more thorough.
 Source: thisoldhouse.com
Source: thisoldhouse.com
Hand sanitizer may kill viruses and certain bacteria but it does not clean your hands like soap and. Soap and water are also part of a hand-cleansing routine thats. Soap and water is more. When were talking about hand sanitizer vs soap portability is a key factor. However without the use of water hand sanitizer uses the active ingredient of alcohol to.
 Source: pinterest.com
Source: pinterest.com
Hand sanitizers work in very much the same way as water and soap. Hand sanitizer may kill viruses and certain bacteria but it does not clean your hands like soap and. However without the use of water hand sanitizer uses the active ingredient of alcohol to. Soap and water are more effective than hand sanitizers at removing certain kinds of germs like Cryptosporidium norovirus and Clostridium difficile 1-5. Youve seen them everywhere.
 Source: thisoldhouse.com
Source: thisoldhouse.com
March 4 2020. An ABC News report tested alcohol-based hand sanitizers antibacterial soap and regular soap and found that alcohol-based hand sanitizers were able to. Hand Sanitizer in Daycare Centers. Thats because soap and water are simply more thorough. Should you wear a mask.
 Source: youtube.com
Source: youtube.com
Soap and water are also part of a hand-cleansing routine thats. Soap and water is more. Keeping their hands clean is a big. Should you use soap and water or hand sanitiser. Hand sanitizer may kill viruses and certain bacteria but it does not clean your hands like soap and.
 Source: pinterest.com
Source: pinterest.com
Soap and water works to remove all types of germs from your hands while hand sanitizers acts by killing certain germs on the skin. The handwashing debate gets an ans. Soap and water is more. Washing your hands with soap and water or rubbing an alcohol-based hand sanitizer is the most. While I am an advocate for hand hygiene I am not an advocate in the community for the overuse of alcohol-based hand rubs or medicated soaps Old-fashioned soap.
 Source: in.pinterest.com
Source: in.pinterest.com
Should you wear a mask. Which one should you use. Hand Sanitizer in Daycare Centers. Should you wear a mask. Hand Sanitizers vs.
 Source: thisoldhouse.com
Source: thisoldhouse.com
Interestingly enough the Food and Drug Administration in regards to regulations concerning proper procedures for food. Soap and water works to remove all types of germs from your hands while hand sanitizers acts by killing certain germs on the skin. Soap and water is more. ABC News reported that during the pandemics first months eBay banned the sale of hand sanitizer disinfectant wipes and surgical masks by US. Kids who cleaned their hands using hand sanitizer instead of soap and water missed less school according to a new study.
Source: healingtreeproducts.com
Source: healingtreeproducts.com
Washing your hands with soap and water or rubbing an alcohol-based hand sanitizer is the most. Hand sanitizer vs. The handwashing debate gets an ans. Hand sanitizer is more portable. ABC News reported that during the pandemics first months eBay banned the sale of hand sanitizer disinfectant wipes and surgical masks by US.
 Source: abcnews.go.com
Source: abcnews.go.com
March 4 2020. Interestingly enough the Food and Drug Administration in regards to regulations concerning proper procedures for food. An ABC News report tested alcohol-based hand sanitizers antibacterial soap and regular soap and found that alcohol-based hand sanitizers were able to. Hand sanitizer may kill viruses and certain bacteria but it does not clean your hands like soap and. Soap and water works to remove all types of germs from your hands while hand sanitizers acts by killing certain germs on the skin.
 Source: abc7chicago.com
Source: abc7chicago.com
The handwashing debate gets an ans. Hand sanitizer vs. Hand Sanitizer in Daycare Centers. Soap and water are more effective than hand sanitizers at removing certain kinds of germs like Cryptosporidium norovirus and Clostridium difficile 1-5. Should you wear a mask.
 Source: hsmemagazine.com
Source: hsmemagazine.com
For this reason the CDC recommends soap and water as the primary most effective germ-buster. CINCINNATI WKRC - Whats better at fighting germs and keeping you from getting sick– hand washing or hand sanitizers. Should you use soap and water or hand sanitiser. Hand sanitizers work in very much the same way as water and soap. Hand Sanitizer in Daycare Centers.
This site is an open community for users to do submittion their favorite wallpapers on the internet, all images or pictures in this website are for personal wallpaper use only, it is stricly prohibited to use this wallpaper for commercial purposes, if you are the author and find this image is shared without your permission, please kindly raise a DMCA report to Us.
If you find this site beneficial, please support us by sharing this posts to your own social media accounts like Facebook, Instagram and so on or you can also bookmark this blog page with the title abc news on hand sanitizer vs soap and water by using Ctrl + D for devices a laptop with a Windows operating system or Command + D for laptops with an Apple operating system. If you use a smartphone, you can also use the drawer menu of the browser you are using. Whether it’s a Windows, Mac, iOS or Android operating system, you will still be able to bookmark this website.
Category
Related By Category
- 29++ Abc news obama ordersnewvote information
- 41+ Abc news insomniac kitchen info
- 13++ Abc news mooresville nc info
- 46+ Abc news iran sanctions ideas in 2021
- 26++ Abc news philly facebook ideas in 2021
- 32+ Abc news interview with luke bryan ideas in 2021
- 42++ Abc news parasailing ideas
- 14+ Abc news parents cry teenager killed by drunk driver info
- 20+ Abc news phoenix phone number ideas
- 47++ Abc news fire tornado ideas